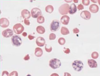
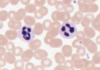
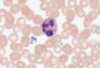
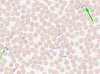
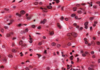

Histology formative questions Flashcards
(148 cards)
What diameter are neurone cell bodies?
20-65nm
How many axon/dendritic processes does each motor neurone have?
0-5
What is the diameter of a lymphocyte?
3.5-6.5um
Are lymphocytes metabolically active?
Not really
Do lymphocytes have lots of Nissl substance?
No, they are relatively dormant
What is the average diameter of a thyroid follicle cell?
70nm
In micrometres, how wide are muscle fibres?
10um
What is chromatin?
Nuclear DNA plus proteins
Where in the body might you find this epithelium?
- Inside the gallbladder
- Inside the mouth
- Lining the inside of the small intestine
- Lining the large airways
- Lining the outside of the small intestine

5.Lining the outside of the small intestine. This is a simple squamous epithelium, single layer of flattened cells with cylindrical/elliptical nuclei of the type found lining the outside of the intestine.
Which stain has been used in the image above to demonstrate the microvillous brush boarder?
- Alcian blue
- H+E
- Iron haematoxylin
- PAS
- Perls

- PAS. These are intestinal villi stained by the PAS procedure (magenta pink stain) and with haematoxylin (blue stain). The wine-glass shaped goblet cells stain dark pink as does the brush border. The nuclei of the columnar epithelial cells stain blue.
Which of the statements concerning the image above is TRUE?
- The cells with eosinophilic cytoplasm are a simple columnar epithelium
- The cells with eosinophilic cytoplasm are ciliated
- The cells with eosinophilic cytoplasm have a secretory function
- The cells with haematoxyphilic cytoplasm have a secretory function
- This is a sample from the large intestine

4.The cells with haematoxyphilic cytoplasm have a secretory function. The cells with eosinophilic cytoplasm in the centre of the image are forming a simple cuboidal epithelium and they are lining a duct within a salivary gland. They are not ciliated and do not have a secretory function. The cells with abundant haematoxyphilic cytoplasm around the periphery of the image are secretory cells.
What is the typical thickness, in micrometres of these layers of cells?
1) 0.5
2) 0.7
3) 1.0
4) 1.5
5) 2.0

3) 1.0. This is a picture of lung showing air sacs (alveoli) whose walls are formed from capillaries and flattened squamous cells. The arrows point to areas of thin air-blood barrier which is typically 1 micrometre thick.
Which of the following statements concerning the image above is FALSE?
- All of the cells in this epithelium are in contact with the basement membrane
- The epithelium contains some cells which secrete mucus
- This epithelium is ciliated
- This is a pseudostratified columnar epithelium
- This is a stratified columnar epithelium

- This is a stratified columnar epithelium.
This is pseudo-stratified columnar ciliated epithelium from the trachea. All of the epithelial cells are anchored to the basement membrane. The cells with pale cytoplasm are goblet cells that secrete mucus.
The PAS procedure can be used to stain goblet cells and the brush border. What other structure will be stained by PAS?
- Basement membrane
- Mitochondria
- Nuclei
- Rough endoplasmic reticulum
- Smooth endoplasmic reticulum
- Basement membrane. The PAS procedure stains hexose sugar containing structures dark (magenta) pink. Typically the basement membrane immediately below and epithelium stains heavily because it contains hexose sugar containing glycoproteins.
Apart from the respiratory tract, where else in the human body can cilia be found routinely?
- Duodenum
- Fallopian tube
- Gallbladder
- Retina
- Urinary bladder
- Fallopian tube. The only other location for a ciliated epithelium is the female genital tract, specifically the fallopian tube.
In the epithelium above, where are the stem cells located?
- Stratum basale
- Stratum corneum
- Stratum granulosum
- Stratum lucidum
- Stratum spinosum

- Stratum basale. In the basal layer (Stratum basale). This is the layer most removed from the surface. From here daughter cells migrate up though the layers until they reach the surface, whereupon they are shed (desquamated)
Which two proteins are principally involved in the generation of ciliary movement?
- Actin and myosin
- Actin and tubulin
- Collagen and elastin
- Tubulin and dyneine
- Tubulin and myosin
- Tubulin and dyneine. The main 2 proteins are tubulin and dyneine. Collagen and elastin are not contractile proteins, and actin and myosin while contractile are found in muscle cells.
Which statement concerning the tight junctions in the epidermal lining of the gut is NOT one of their functions?
- To allow the passage of water and glucose between the cells
- To generate a concentration gradient across the epithelium
- To hold cells together
- To permit the passage of signal molecules from cell to cell
- To prevent the passage of large molecules between the cells
- To permit the passage of signal molecules from cell to cell. Tight junctions hold the cells together to prevent large molecules from passing between them and gaining access to the interior of the body. With tight junctions intact the epithelium acts as a barrier and can establish a gradient for the absorption of secretion of molecules from or into the gut. Only water and some selected small molecules (e.g. glucose) are able to breach this barrier. The passage of signal molecules from cell to cell is a function of gap junctions.
Concerning the image above, which cell type is responsible for producing this type of connective tissue (stained brown)?
- Elastoblasts
- Elastocytes
- Fibroblasts
- Fibrocytes
- Hepatocytes

- Fibroblasts. This is a transverse section through the wall of a carotid artery stained for elastic tissue. The thick medial layer contains many concentric layers (sheets) of elastic tissue that stain brown (elastic Van Gieson stain). This elastic tissue replaces the smooth muscle found in this layer in muscular arteries. Like collagen, elastin is produced by fibroblasts. Elastoblasts, elastocytes and fibrocytes do not exist. Hepatocytes make fibrin.
Which type of collagen forms the basement membranes of epithelia?
- Type I
- Type II
- Type III
- Type IV
- Type V
- Type IV
Basement membranes are formed from Type IV collagen.
Type I - Skin, bone, teeth, capsules of organs
Type II - Cartilage
Type III - Liver, kidney, spleen, arteries, uterus
Type IV - Basement membranes
Type V - Placenta
The image above shows liver stained to reveal the fine reticular framework (stained black). What type of collagen is this?
- Type I
- Type II
- Type III
- Type IV
- Type V

- Type III. The coarser elements of this framework are often composed of Type I collagen but the fine framework is made of Type III collagen fibrils referred to histologically at reticular fibres or reticulin. The tissues of the reticulo-endothelial system (lymph nodes, spleen, liver etc.) are particularly rich in Type III collagen.
What structural feature sets reticulin apart from other types of collagen
- It can be readily seen on an H+E stained section
- It can be stretched
- It forms branched fibres
- It forms straight linear fibres
- It is produced by hepatocytes
- It forms branched fibres. Unlike the other types of collagen, which tend to form in linear fibres, reticulin forms branched fibres. It is not easily seen on H+E stained sections and special stains are required. All types of collagen lack elasticity and therefore cannot be stretched. Reticulin is not produced by hepatocytes.
Which of the following statements concerning the image above is TRUE?
- This is dense elastic connective tissue
- This is dense fibrocollagenous tissue
- This is type III collagen
- This is type IV collagen
- This tissue contains branching collagen fibres

- This is dense fibrocollagenous tissue. This image shows regularly arranged pink staining collagen fibres within a tendon. Fibroblast cells with blue staining nuclei are sandwiched between the fibres. Tendons contain type I collagen (type III is reticulin and type IV forms basement membranes). Type I collagen forms linear fibres.
Which of the following statements concerning collagen formation is TRUE?
- Individual collagen fibrils are formed from linear strands of tropocollagen lined end-to-end
- The polypeptide chains within tropocollagen are wound into a beta-helix
- Tropocollagen molecules are 300nm long
- Tropocollagen subunits are assembled into fibrils prior to excretion from the cell
- Tropocollagen subunits contain 5 linear polypeptide chains
- Tropocollagen molecules are 300nm long. Individual collagen fibrils consist of overlapping linear strands of tropocollagen. Tropocollagen is synthesized within fibroblasts and other cell types. Tropocollagen molecules are secreted from cells and assembled into fibrils extra-cellularly. Overlapping of the linear tropocollagen units gives rise to characteristic banding to the collagen fibrils. Individual fibrils are often aligned side-by side to create larger collagen fibres of variable thickness. Each tropocollagen subunit is 300nm long and consists of 3 linear polypeptide chains, (usually two similar and one dis-similar chains) wound together in an alpha helix.